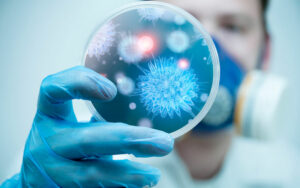

Trending
- ABCDE‑módszer: így ismerhetjük fel korán a gyanús bőrelváltozásokat
- Nem csak fáradtság: idegrendszeri tünetek, amiket sokan figyelmen kívül hagynak
- Az egész érrendszer egy kézben – miért fontos az átfogó állapotfelmérés?
- Természetes megjelenés, nem feltűnő változás – mit várhatunk ma az esztétikai kezelésektől?
- Magas vérnyomás nőknél: sokan tudnak róla, mégsem lépnek
- Új remény a pikkelysömör kezelésében – de mit tehetünk már ma?
- Nem csak aranyér: tünetek, amiket sokan túl sokáig halogatnak
- Tél után a bőrünk is megújul. Mire figyeljünk tavasszal?